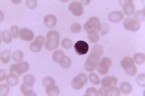

Neurología
La nicotina activa receptores en el cerebro que reducen el apetito
Un nuevo estudio, publicado en la revista Science, revela cómo la nicotina activa un grupo de neuronas del hipotálamo que transmiten sensación de saciedad. Los resultados contribuirán al desarrollo de nuevos tratamientos para controlar el peso de los exfumadores –con tendencia a engordar cuando abandonan este hábito-, y de las personas con obesidad.
Investigadores norteamericanos han descubierto por qué los fumadores suelen, en general, pesar menos que los no fumadores. Según el estudio, publicado en la revista Science, la nicotina, uno de los principales factores de adicción al tabaco, suprime la sensación de apetito.
Los experimentos realizados en ratones muestran que esta sustancia activa un conjunto de receptores neuronales, diferentes a los que suscitan las ansias de fumar, que se sitúan en el sistema de melanocortina del hipotálamo. Este sistema se encarga de distribuir la energía extra que aportan los alimentos, metabolizándola o almacenándola en forma de grasa.
Además, tal y como señala Marina Picciotto, autora principal del estudio e investigadora del departamento de psiquiatría de la Escuela de Medicina de la Universidad de Yale (EE UU), “es posible suprimir la sensación de apetito sin afectar los centros de recompensa del cerebro”.
Y es que estos receptores aumentan la actividad de una serie de neuronas cerebrales, conocidas como células proopiomelanocortina o POMC, que se relacionan con la obesidad en humanos y animales. Los resultados revelaron que los ratones que carecían de las neuronas POMC no perdieron peso, a diferencia de los ratones que sí las tenían.
![[Img #2916]](upload/img/periodico/img_2916.jpg)
El tabaquismo es la principal causa de muerte prevenible en los países desarrollados, pero hay personas, sobre todo mujeres, que se niegan a dejar de fumar por temor a engordar.
“Identificar estos receptores ayudará a conocer los mecanismos asociados a la adicción, el peso y el hábito de fumar”, señala Mariella de Biasi, también autora del estudio e investigadora del departamento de Neurociencias del Colegio de Medicina Baylor de Houston (EE UU).
Aunque los resultados de la investigación solo se han obtenido en ratones, “podrían ser claves para el desarrollo de fármacos que ayuden a los fumadores a abandonar el tabaco sin ganar peso”, subraya la científica. Además, “estos medicamentos también permitirían controlar la obesidad y los desórdenes metabólicos de otras personas”, concluye. (Fuente: SINC)